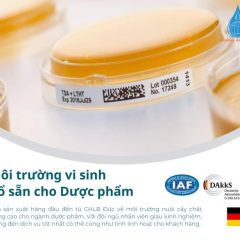
PMM-Môi Trường Vi Sinh

Tổng số phụ: 0₫
BACGro Dextrose (Glucose) / 10kg
- Mã sản phẩm: DCM9910
- Tình trạng: Còn hàng
- Xuất xứ: Hungary
0₫
Danh mục: KIT GOLD STANDARD DIAGNOSTICS, Media, Tất cả sản phẩm
Thẻ: Kit, Media, Test nhanh
BACGro Dextrose (Glucose) / 10kg
Phụ kiện sản phẩm
Tìm tài liệu sản phẩm trong Kho lưu trữ tài liệu
Thông số kỹ thuật
| Mã sản phẩm | DCM9910 |
| Bảo quản | 2-30 °C |

 Bộ tách chiết DNA bộ gen TrusPure
Bộ tách chiết DNA bộ gen TrusPure

Đánh giá
Chưa có đánh giá nào.